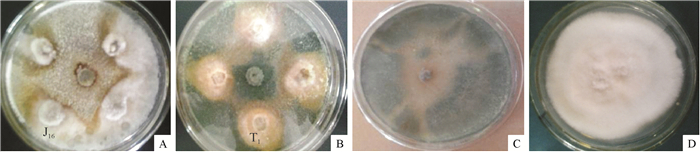

苹果树Malus pumila Mill.属蔷薇科Rosaceae苹果属Malus。苹果树腐烂病是苹果生产上一种极为严重的病害,由黑腐皮壳属Valsa(无性型为壳囊孢属Cytospora)真菌引起的。该病发生区域广、发病率高、防治困难,发病严重的果园树体枝干残缺,甚至造成大量死树或毁园[1];苹果炭疽病又名苦腐病、晚腐病,是由子囊菌亚门小丛壳菌Glomerella cingulata所致,传播速度快,已成为阻碍苹果生产的主要病害[2-4]。苹果是我国陕北农业的支柱,近年来遭受到多种病害的侵染,尤其是苹果树腐烂病与苹果树炭疽病[5]。
植物内生真菌是指在植物寄主体内度过全部或近乎全部生活周期而不使寄主表现任何症状的一类真菌。内生真菌可能产生与宿主相同或相似的次生代谢产物,这些次生代谢产物是一些抗生素类和水解酶类等物质,能影响病原菌的生长,最终导致其死亡[6]。许多内生真菌的代谢产物具有农药活性,利用植物内生真菌来开发生物农药,是解决化学农药抗性、残留和再猖獗问题的有效途径之一[7]。王现坤等[8]的研究表明内生真菌中链格孢属拮抗菌群对苹果树腐烂病的拮抗作用较强;蔡光华等[9]研究表明苹果树腐烂病拮抗内生细菌PG-10-8-11v菌株在高温、紫外光的条件下具有较好的抑菌效果;邓振山等[10]研究了银杏Ginkgo biloba L.叶片和茎内生真菌对苹果树腐烂病菌的抑制作用;郭建新等[11]从银杏根、茎、叶和果实中分离出的522株内生真菌中有21.64%的菌株发酵液对苹果树炭疽病菌有较强的抑制作用;徐涛等[12]通过对健康苹果树树皮内生真菌的分离筛选出了对苹果树腐烂病菌生长有抑制作用的拮抗真菌,并且鉴定其主要为链格孢属真菌。但鲜见利用内生真菌同时来防治苹果树腐烂病和苹果树炭疽病的研究报道。本研究对发病地段的健康苹果树不同部位以及根际土壤中的内生真菌进行了分离,并对筛选出的拮抗真菌进行了液体培养,检测了发酵滤液和菌丝体提取物对2种病原菌的抑菌活性以及抑菌物质的热稳定性,旨在确定它们的抑菌特性,为进一步研究其内生拮抗真菌代谢产物的化学成分及作用机理奠定基础。
1 材料与方法 1.1 供试材料2013年从延安市宝塔区枣园苹果种植园发病区的健康果树上采集根、茎(采集的根和茎的木质化程度要低且根系不要须根)以及苹果树的根际土壤,进行内生真菌的分离。
苹果树腐烂病菌Valsa malimiyabe、苹果树炭疽病菌Glomeralla cingulata病原菌由延安大学生命科学学院微生物实验室鉴定并保藏。
PDA培养基:马铃薯200 g·L-1、葡萄糖20 g·L-1、琼脂20 g·L-1,;改良的PDA培养基:马铃薯200 g·L-1、苹果树枝碾碎磨粉100 g·L-1、葡萄糖20 g·L-1、琼脂20 g·L-1;30%ABA培养基[13]:苹果树枝碾碎磨粉300 g·L-1、琼脂20 g·L-1、水1 L。
1.2 方法 1.2.1 内生真菌的分离和纯化内生真菌采用组织块培养[14]。在超净工作台上,将采集的苹果树根、茎,分别用清水洗净表面附着的杂质后进行表面消毒(在φ为75%的乙醇溶液中浸泡1 min,无菌水冲洗3次,再用w为0.1%的氯化汞溶液浸泡60~90 s,无菌水冲洗5次),灭菌滤纸吸干多余水分后,用灭菌剪及灭菌刀将材料切割为6~8段(每段约0.3~0.5 mm),将表面消毒的材料分别置于改良的PDA培养基、30%ABA培养基和PDA培养基平板中,每培养皿3~5段,28 ℃恒温静置培养5~6 d。根际土壤经晾晒、研磨后用无菌水浸泡,28 ℃恒温摇床振荡12 h,取悬浊液,采用系列稀释法,在PDA培养基上涂布,28 ℃恒温培养5~6 d。定期观察,采用菌丝尖端挑取法,根据菌丝颜色、形态以及长出的先后顺序,挑取组织切口处长出的菌丝转接到新的PDA培养基上培养,反复纯化直至获得单一菌株,斜面保存并编号备用。经表面消毒不做处理的材料在培养基上作组织印迹对照处理,检验消毒效果。
1.2.2 拮抗菌株的筛选依据文献[15],采用平板对峙法进行。以苹果树腐烂病和苹果树炭疽病病原菌为靶标,将病原菌接种于PDA平板进行活化,28 ℃下培养至病原菌长满平板,用灭过菌的4 mm打孔器分别对纯化的内生真菌和病原菌打孔,采用四点对峙法(在含有20 mL PDA的平板两端相距3 cm处放置直径为4 mm的生长旺盛的病原菌和内生真菌菌饼),每处理重复3次,以各4 mm病原菌饼圆盘为对照,28 ℃恒温培养箱培养,待对照组和试验组培养4 d后, 采用十字交叉法测量对照组直径(D对照)和处理组直径(D处理),计算抑制率。

|
无菌条件下,将保存的内生真菌接种到PDA平板上,28 ℃培养5 d活化,将活化的内生真菌再分别接种到500 mL PDA的三角瓶发酵培养基中,于28 ℃、180 r·min-1培养10 d后,5 000 r·min-1离心5 min取上清液,并经过0.22 μm的微孔滤膜真空抽滤,滤液收集、保存备用。
菌丝提取物的制备及处理方法参照文献[16]。菌丝体50 ℃条件下烘干,研磨成粉末后按照1 g菌丝体加9 mL φ为95%的乙醇溶液的比例在45 ℃水浴条件下分3次提取,3次提取时间分别为24、4和2 h,最后水浴除去溶剂,烘干并保存提取物备用。
拮抗活性测定采用生长速率法[17]。取内生真菌发酵液10 mL,加90 mL灭菌的PDA培养基混匀后倒平板,对照组加等量的无菌水。用直径4 mm的打孔器在培养5 d的供试病原真菌的菌落边缘打取菌饼,再将菌饼菌丝面朝下接种到含发酵液的培养基平板正中央。取菌丝提取物用无菌水配制0.1 g·mL-1的溶液,取10 mL该溶液加入90 mL灭菌的PDA培养基混匀后倒平板,对照组同样加等量的无菌水。含菌丝提取物的PDA培养基平板接种方法同上。每个处理设3次重复,28 ℃恒温培养5 d,采用十字交叉法测量对照组和处理组直径,计算抑制率。
1.2.4 内生真菌发酵液对病原菌孢子萌发的影响将病原真菌接种至改良的PDA培养基上,恒温培养4 d后,转接到30% ABA培养基上,培养7 d,待菌落表面产生大量突起的分生孢子器和分生孢子丝后,在超净工作台上,用灭菌的打孔器打取4 mm菌饼,挑取到无菌的试管中,加入无菌水,振荡搅动使培养基的孢子尽可能多地存在于水中,取1滴于显微镜下观察,根据文献[18]的标准,在低倍镜(10×10)下的视野内孢子数达到50~90个。
在无菌条件下,用移液枪吸取孢子悬液300 μL于1.5 mL的小离心管中,加入同等体积的内生真菌发酵液,再加入200 μL的PDA液体培养基,振荡混匀后,对照加同等体积的无菌水,28 ℃恒温水浴12 h后,镜检孢子萌发情况,并计算孢子萌发率和孢子萌发的抑制率。
孢子萌发率=(萌发孢子数/孢子调查数)×100%,
孢子萌发的抑制率=(对照孢子萌发率-处理孢子萌发率)/对照孢子萌发率×100%。
1.2.5 发酵液的热稳定性J2、J11、J16、J17、T1发酵液经过无菌滤纸和0.22 μm微孔滤膜过滤,在无菌条件下取15 mL于灭菌试管中,经过20(CK)、40、60、80、100 ℃水浴加热和121 ℃高温灭菌处理30 min[19],冷却到室温,在超净工作台中,取处理过的发酵液加入100 mL的已灭菌并且温度降至50 ℃以下的PDA培养基中,充分混匀后,在灭菌平板中倒入约15 mL,待培养基凝固后,采用平板打孔法,在相应的固体培养基中央接入4 mm的苹果树腐烂病菌饼、苹果树炭疽病菌饼,以28 ℃发酵液作为对照,每个处理重复3次,28 ℃恒温培养48 h,用十字交叉法测量苹果树腐烂病菌和苹果树炭疽病菌的直径,计算抑制率。
1.3 数据处理试验数据采用SPSS 21.0软件进行数据统计和显著性分析。
2 结果与分析 2.1 内生真菌的分离和纯化从病区健康苹果树的根、茎及其根际土分离得到真菌共有18株。通过形态学对内生真菌进行初步鉴定,分离得到的内生真菌分属3个属,包括链格孢属Alternaria sp.、茎点霉属Phoma sp.和球壳孢属Sphaeropsis sp.。不同部位真菌的种类和数量也存在差别,其中茎部分离的菌株数最多,为9株,其次是根部5株,根际土4株。其中链格孢属为苹果树茎和根部占绝对优势的内生真菌菌株,占总分离频率的50.0%(表 1)。
|
|
表 1 不同部位的真菌分离结果 Table 1 Isolated fungi from different parts of apple tree |
对峙试验结果(表 2)表明,共有8株真菌对苹果树腐烂病菌和苹果树炭疽病菌的生长有抑制作用,占供试菌株总数的44%。其中有5株真菌对苹果树腐烂病菌和炭疽病菌的生长均有抑制作用,另有3株真菌对苹果树腐烂病菌或炭疽病菌的生长分别有不同的抑制作用,不同真菌菌株对苹果树腐烂病菌菌丝生长的抑制率有一定差异,其中抑制率在80%以上的有J2、J16、J17 ,对苹果树腐烂病菌的生长抑制率分别达82.75%、84.31%、82.35%。除J11和T4无抑制作用外,剩余的菌株对苹果树腐烂病菌生长的抑制率集中于60%~70%;T1内生真菌对苹果树炭疽病菌的抑制率最高,达80.67%,除T3菌株无抑制作用外,其他6株内生真菌对苹果树炭疽病菌的抑制率均大于70%。
|
|
表 2 苹果拮抗真菌对苹果树腐烂病菌菌丝生长的抑制作用1) Table 2 Inhibiory effects of antagonistic fungi on mycelial growth of Valsa ceratosperma and Glomeralla cingulata in apple tree |
如图 1a所示,在抑菌带的边缘,苹果树腐烂病菌的菌丝体分布不均、明显变薄、颜色变成褐色,菌丝的生长受到明显的抑制,其对照组(图 1c)苹果树腐烂病菌在接种第4天后迅速长满整个平板,J16(图 1a)和T1(图 1b)分别对苹果树腐烂病菌和苹果树炭疽病菌的生长抑制较为明显,抑菌带周围的菌丝体分布不均、颜色变成褐色。
|
图 1 内生真菌对苹果树腐烂病菌及苹果树炭疽病菌的拮抗作用 Figure 1 Inhibitory effects of endophytic fungi on Valsa ceratosperma and Glomeralla cingulata in apple tree a:接种内生真菌J16和苹果树腐烂病菌; b:接种内生真菌T1和苹果树炭疽病菌; c:苹果树腐烂病菌; d:苹果树炭疽病菌。 |
由表 3可知,不同拮抗真菌发酵后的滤液对苹果树腐烂病菌和炭疽病菌菌丝生长的抑制作用差别较大,对苹果树腐烂病菌的抑制率最大为77.14%,对苹果树炭疽病菌的抑制率最大为76.22%,其他菌株的抑制率都大于60%。菌丝提取物对病原菌菌丝的生长抑制作用不显著,其中对病原菌生长有较强抑制作用的拮抗真菌J16和T1,最大抑制率均小于9%。
|
|
表 3 发酵液和菌丝体提取物对病原菌菌丝生长的抑制作用1) Table 3 Inhibition rates of sterile fermentation filtrates and extracts from endophytic fungal mycelium on mycelial growth of pathogen |
内生真菌发酵液对苹果树腐烂病和苹果树炭疽病分生孢子萌发有抑制作用,且不同菌株的发酵液对分生孢子萌发的抑制作用有较大差异。从表 4中可以看出,除J11和T4外,所测的菌株对苹果树腐烂病菌孢子萌发的抑制率均大于45%,其中对苹果树腐烂病菌分生孢子萌发抑制作用最强的为J16,抑制率为69.75%;除T3外,其他菌株对苹果树炭疽病菌分生孢子萌发抑制率均不小于39.55%,其中作用最强的为T1,抑制率为69.43%,但内生真菌的发酵液对2种病原菌孢子萌发抑制率均小于70%,分析可能是发酵液中的活性物质浓度不足。
|
|
表 4 内生真菌发酵液对苹果树腐烂病菌和炭疽病菌分生孢子萌发的抑制作用1) Table 4 Inhibitory effect of zymotic fluid of antagonistic fungi on conidial germination of Valsa ceratosperma and Glomeralla cingulata in apple tree |
由表 5可知,J2发酵液作用的菌落直径随温度升高而变大,且60~121℃与对照相比差异显著,在温度超过100 ℃时,抑制率为0,表明此抑制物质可能因高温失去生物活性。除121℃外,J16发酵液作用的菌落直径相对于对照组并未随温度升高存在显著差异,说明其抑制物质对热具有较好的稳定性。J17随温度的升高抑菌效果不断提高,但与对照相比均无显著差异,到121 ℃时抑制率为17.2%,说明温度对其无菌滤液的影响较小。
|
|
表 5 苹果树腐烂病菌拮抗真菌J2, J16和J17发酵滤液的热稳定性 Table 5 Heat stability of zymotic fluid of antagonistic fungi J2, J16 and J17 against Valsa ceratosperma |
由表 6可知,与对照相比,菌株J2发酵液作用的病原菌直径随温度的升高而显著增加,且最大直径达到8.10 cm,与对照组相比,其抑制率随温度升高而降低,且在100 ℃和121 ℃时,抑制率为0,这可能是由于发酵滤液中含有的抑菌蛋白物质因高温作用生物活性降低所致;而J11和T1发酵液对温度的稳定性较好,可能是发酵液中含有非蛋白物质,且此物质具有较好的热稳定性。
|
|
表 6 苹果树炭疽病菌拮抗真菌J2, J11和T1发酵滤液的热稳定性1) Table 6 Heat stability of zymotic fluid of antagonistic fungi J2, J11 and T1 against Glomeralla cingulata |
本研究从苹果树发病地段健康植株的根、茎以及苹果树的根际土壤中筛选出具有抑制苹果树腐烂病菌和苹果树炭疽病菌的18株内生拮抗真菌,并分别归于3个属,其中链格孢属内生真菌是优势菌株,占总分离菌株的50.0%。这与徐涛等[12]的研究结果一致,该研究从苹果树不同部位枝干的树皮中分离得到抑制苹果树腐烂病菌13个属的内生真菌,其中链格孢属内生真菌是优势菌株,占总分离菌株的73.27%。球壳孢属是本研究新报道的内生真菌属,其他属真菌已有相关报道[12]。对峙试验结果表明,分离到的8株内生真菌中,有5株分别对苹果树腐烂病和苹果树炭疽病的抑菌率超过67.00%,其中T1对苹果树炭疽病的抑制率达到80.67%。发酵滤液都至少对2种病原菌有大于60%的抑菌活性,并且其中J2、J16、J17的发酵滤液对苹果树腐烂病的抑制率分别为82.75%、84.31%、82.35%。
展丽然[20]研究了土壤中放线菌对苹果树腐烂病菌的抑制作用,并优化了拮抗放线菌的发酵条件。王东昌等[21]从苹果树上分离到了拮抗菌株AT9706,在室内测定其对苹果树腐烂病菌的抑制效果达到了100%,田间采用AT9706制剂的防治效果达到了95%。Xin等[22]从毛百杨Populus tomentosa上分离到1株对苹果树腐烂病菌有较好拮抗作用的内生螺旋毛壳Chaetomium spirale菌株ND35,温室接种试验表明,用ND35处理的苹果树腐烂病的发生率明显的比用其他方法处理的果树低。以上研究仅是针对一种病原真菌筛选拮抗内生菌,并且多数为其他种植物的内生菌。郭晓等[23]研究表明,螺旋毛壳菌ND35分泌的胞外酶β-1, 3-葡聚糖酶对苹果树炭疽病菌、杨树腐烂病菌Valsa sordida以及苹果树腐烂病菌的菌丝生长和孢子的萌发有明显的抑制作用。本试验通过对发病地段的健康苹果树不同部位进行筛选后得到同时抑制苹果树腐烂病菌和苹果树炭疽病菌的拮抗内生真菌,并且抑制作用较为显著。进一步发酵培养试验检测了其内生真菌中抑菌物质的耐热特性,结果表明拮抗真菌J2、J16、J17、J24和T1发酵液对2种病原菌分生孢子萌发抑制率均不小于39.55%,最高可达69.75%,J11和T1无菌滤液的热稳定性较好,说明此无菌滤液中也可能存在类似的抑菌蛋白或其他大分子物质,且对热有较好的稳定性,能引起系统免疫,而J2的无菌滤液在100 ℃时失去了生物活性,可能是抑菌蛋白因高温失去了生物活性或其他大分子物质的热稳定性较差。但是未涉及到对抑菌物质的提取和鉴定,对于菌株的鉴定和田间防治效果还有待于进一步研究。
| [1] |
刘如香. 苹果树腐烂病菌分生孢子的萌发、存活和侵染条件的研究[D]. 保定: 河北农业大学, 2011.
(  0) 0) |
| [2] |
李培夫. 苹果腐烂病防治新技术[J]. 农村科技, 2005(4): 17. DOI:10.3969/j.issn.1002-6193.2005.04.013 (  0) 0) |
| [3] |
杨万宝. 苹果炭疽病发生原因及防治措施[J]. 现代农村科技, 2011(19): 26. DOI:10.3969/j.issn.1674-5329.2011.19.021 (  0) 0) |
| [4] |
王敬尊. 苹果炭疽病的识别与防治[J]. 安徽农业科学, 2009, 37(18): 8560-8561. DOI:10.3969/j.issn.0517-6611.2009.18.105 (  0) 0) |
| [5] |
邓振山, 白重炎, 李军, 等. 陕北苹果常见真菌病害病原菌的分离鉴定研究[J]. 延安大学学报(自然科学版), 2006, 25(4): 65-70. DOI:10.3969/j.issn.1004-602X.2006.04.019 (  0) 0) |
| [6] |
李培, 王永斌. 植物内生真菌的研究与展望[J]. 饮料工业, 2008, 11(7): 11-13. DOI:10.3969/j.issn.1007-7871.2008.07.004 (  0) 0) |
| [7] |
AZEVEDP J L, MACCHERONI J R W, PEREIRA J O, et al. Endophytic microorganisms: A review on tropical plants[J]. Electron J Biotechn, 2000, 3(1): 40-65. (  0) 0) |
| [8] |
王现坤, 张晓华, 赫双红. 侧柏内生真菌的分离鉴定及抗菌活性筛选[J]. 农药, 2010, 49(7): 519-521. DOI:10.3969/j.issn.1006-0413.2010.07.018 (  0) 0) |
| [9] |
蔡光华, 战峰, 王晓玲. 苹果树腐烂病拮抗内生细菌PG-10-8-11v菌株抗菌物质的初步研究[J]. 西南民族大学学报(自然科学版), 2011, 37(6): 945-949. (  0) 0) |
| [10] |
邓振山, 赵龙飞, 张薇薇, 等. 银杏内生真菌的分离及其对苹果腐烂病病原菌的拮抗作用[J]. 西北植物学报, 2009, 29(3): 608-613. DOI:10.3321/j.issn:1000-4025.2009.03.028 (  0) 0) |
| [11] |
郭建新, 孙广宇, 张荣, 等. 银杏内生真菌抗真菌活性菌株的分离和筛选[J]. 西北农业学报, 2005, 14(4): 14-17. DOI:10.3969/j.issn.1004-1389.2005.04.004 (  0) 0) |
| [12] |
徐涛, 胡同乐, 王亚南, 等. 苹果树皮内生真菌的分离及其对腐烂病的生物防治潜力[J]. 植物保护学报, 2012, 39(4): 327-333. (  0) 0) |
| [13] |
周宗山, 徐成楠, 吴玉星, 等. 苹果树腐烂病病菌分生孢子获取方法研究[J]. 中国果树, 2011(2): 41-43. (  0) 0) |
| [14] |
杨润亚, 李艳华, 柳娜娜. 连翘内生真菌的分离及其抑菌活性初步研究[J]. 安徽农业科学, 2007, 35(15): 4561-4563. DOI:10.3969/j.issn.0517-6611.2007.15.085 (  0) 0) |
| [15] |
夏伟, 张红, 颜艳伟, 等. 棘孢木霉L4对立枯丝核菌的拮抗机制[J]. 植物保护学报, 2010, 37(5): 477-478. (  0) 0) |
| [16] |
孙杰, 杨润亚, 任晓明. 三种海藻内生真菌的分离及其抑菌活性研究[J]. 食品科学, 2007(11): 357-359. DOI:10.3321/j.issn:1002-6630.2007.11.082 (  0) 0) |
| [17] |
王艳红, 吴晓民, 朱艳萍, 等. 温郁金内生真菌Chaetomium globosum L18对植物病原菌的抑菌谱及拮抗机理[J]. 生态学报, 2012, 32(7): 2040-2046. (  0) 0) |
| [18] |
蒋继宏, 李晓储, 陈凤美, 等. 植物抽提物对苹果炭疽病菌分生孢子的抑制作用[J]. 江苏林业科技, 2004, 31(4): 23-25. DOI:10.3969/j.issn.1001-7380.2004.04.006 (  0) 0) |
| [19] |
邓振山, 候改成, 孙志宏, 等. 番茄灰霉病菌拮抗菌D6和D10发酵条件的优化及其抑菌效果[J]. 西北农林科技大学学报(自然科学版), 2013, 41(9): 73-77. (  0) 0) |
| [20] |
展丽然. 苹果腐烂病菌拮抗放线菌的筛选、鉴定及发酵条件的优化[D]. 保定: 河北农业大学, 2008.
(  0) 0) |
| [21] |
王东昌, 辛玉成, 郝秀青, 等. 苹果树枝干病害的生物防治[J]. 吉林农业科学, 2001, 26(2): 49-50. DOI:10.3969/j.issn.1003-8701.2001.02.013 (  0) 0) |
| [22] |
XIN Y F, SHANG J J. Bio-control trials of Chaetominum spirale ND35 against apple canker[J]. J Forest Res-Jpn, 2005, 16(2): 121-124. DOI:10.1007/BF02857904 (  0) 0) |
| [23] |
郭晓, 高克祥, 印敬明, 等. 螺旋毛壳ND35 β-1, 3-葡聚糖酶的诱导、性质及其抑菌作用[J]. 植物病理学报, 2005, 35(6): 493-503. DOI:10.3321/j.issn:0412-0914.2005.06.003 (  0) 0) |
 2016, Vol. 37
2016, Vol. 37







